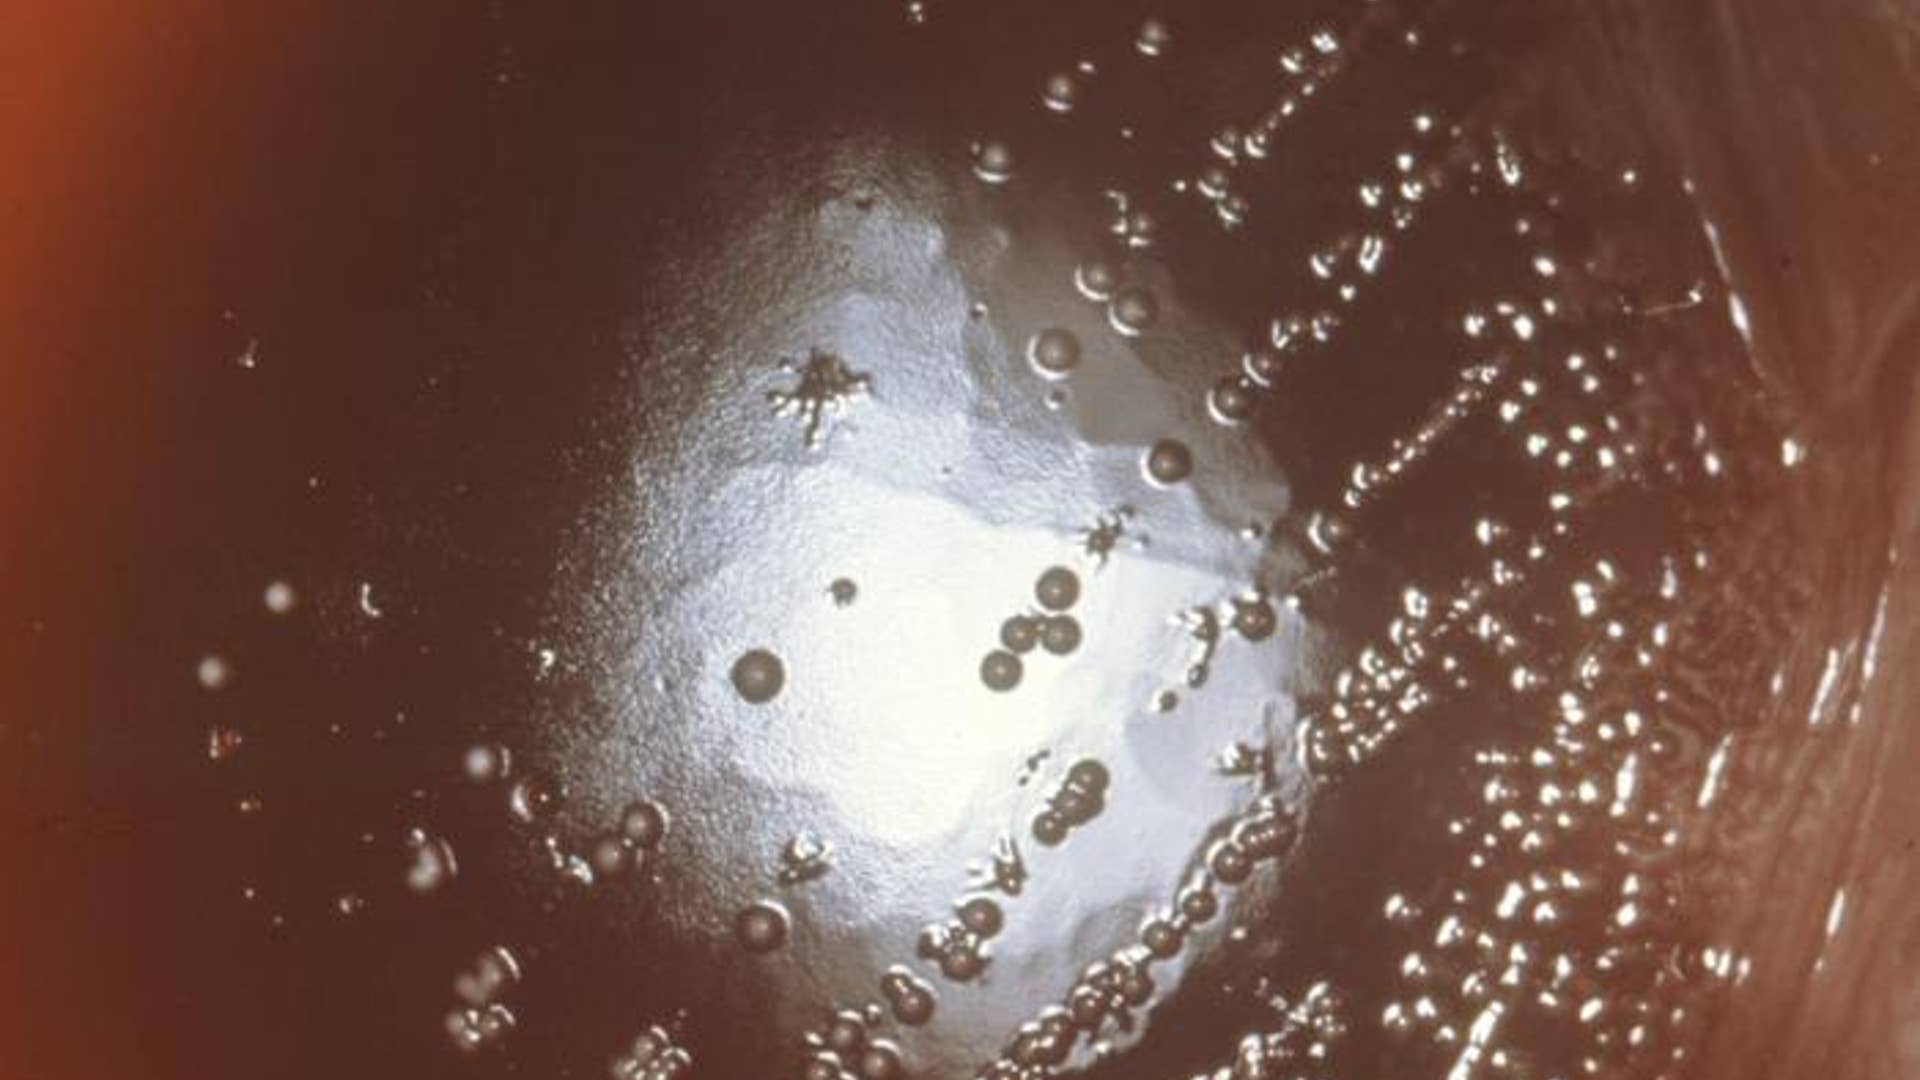
Gas Gangrene

Move Back
ADVERTISEMENT
Skip- Published19 Images
Dangerous Beauty: A Close Look at Deadly Diseases
Scientists get closer to most deadly diseases than you'd ever want to. Here's the only safe view of anthrax, salmonella, and more: through the scientist's microscope.
![smallpox virus micrograph]()
![Salmonella]()
Scientific name: Ebolavirus Created by CDC microbiologist Cynthia Goldsmith, this colorized photo revealed some of the funky structure of an ebola virus. The exact origin, locations, and natural habitat of the virus remain unknown. However, on the basis of available evidence and the nature of similar viruses, researchers believe that the virus is zoonotic (animal-borne) and normally lives in an animal host native to Africa.read moreCDC/ Cynthia GoldsmithShare![Whitmore Disease]()
![Glanders]()
Scientific name: Marburg virus This photo, captured by scientist F.A. Murphy in 1968, depicts a number of Marburg virus virions grown in tissue cells. Marburg hemorrhagic fever is a rare, severe type of hemorrhagic fever that affects both humans and non-human primates.read moreCDC/ Frederick MurphyShare
Scientific Name: Escherichia coli Under a 6,836-fold magnification, the Escherichia coli bacteria (commonly called E. coli) looks more artistic than sickening. Although most strains are harmless, and live in the intestines of healthy humans and animals, this strain produces a powerful toxin, which can cause severe illness.read moreCDC/ National Escherichia, Shigella, Vibrio Reference Unit at CDCShare![Chlamydia]()
Scientific name: Arenavirus A member of the family Arenaviridae, lassa is a single-stranded RNA virus, and is an animal-borne disease that can be transmitted to humans. The illness, which occurs most commonly in West Africa, was discovered in 1969 when two missionary nurses died in Nigeria.read moreCDC/ C. S. Goldsmith, P. Rollin, M. BowenShare
Scientific name: Clostridium Perfringens What is it? A spore-forming, heat-resistant bacterium that can cause foodborne disease -- and the most common bacterial agent for gas gangrene, a potential biohazard. The spores persist in the environment, and often contaminate raw food materials. These bacteria are found in mammalian feces and soil.read moreCDC/ Dr. Gilda JonesShare
This micrograph reveals the first stage of shigellosis -- or bacterial dysentery -- as it progresses. Usually, those who are infected with Shigella develop fever, an often bloody diarrhea, and stomach cramps starting a day or two after they are exposed to the bacterium. Shigellosis usually resolves in 5 to 7 days.read moreCDC/ Dr. Sam Formal, Walter Reed Army Institute of ResearchShare
Scientific name: Cryptosporidium This blue-stained section shows numerous Cryptosporidium organisms at the surface of epithelial cells. Infection leads to Cryptosporidiosis -- Crypto for short -- and it results in a wide range of symptoms, from asymptomatic infections to severe, life-threatening illnesses.read moreCDC/ Dr. Edwin P. Ewing, Jr.Share
Scientific name: Eastern equine encephalomyelitis This micrograph shows a salivary gland extracted from a mosquito infected by the Eastern equine encephalitis virus. Due to the high case fatality rate, it is regarded as one of the more serious mosquito-borne diseases in the United States.read moreCDC/ Fred Murphy; Sylvia WhitfieldShare![Botulism]()
Scientific name: Bacillus Anthracis Under a very high magnification of 31,207X, this scanning electron micrograph captures spores from the Sterne strain of anthrax bacteria. These spores can live for many years, which enables the bacteria to survive in a dormant state.read moreCDC/ Laura RoseShare
Scientific name: Vibrio Cholerae This scanning electron micrograph depicts a number of cholera bacteria, photographed as two were about to complete the process of cellular division. Cholera is an acute diarrheal illness caused by infection of the intestine with the bacterium Vibrio cholerae.read moreCDC/ Janice CarrShare![Plague]()
Scientific name: Francisella Tularensis Tularemia, also known as "rabbit fever," is a disease caused by the bacterium Francisella tularensis. Tularemia is typically found in animals, especially rodents, rabbits, and hares. Tularemia is usually a rural disease and has been reported in all U.S. states except Hawaii.read moreCDC/ Courtesy of Larry Stauffer, Oregon State Public Health LaboratoryShare![Western Equine Encephalitis]()
- Published19 Images
Dangerous Beauty: A Close Look at Deadly Diseases
Scientists get closer to most deadly diseases than you'd ever want to. Here's the only safe view of anthrax, salmonella, and more: through the scientist's microscope.
Move Forward
- Dangerous Beauty: A Close Look at Deadly Diseases



















Thumbnail View
Image 0 of 19